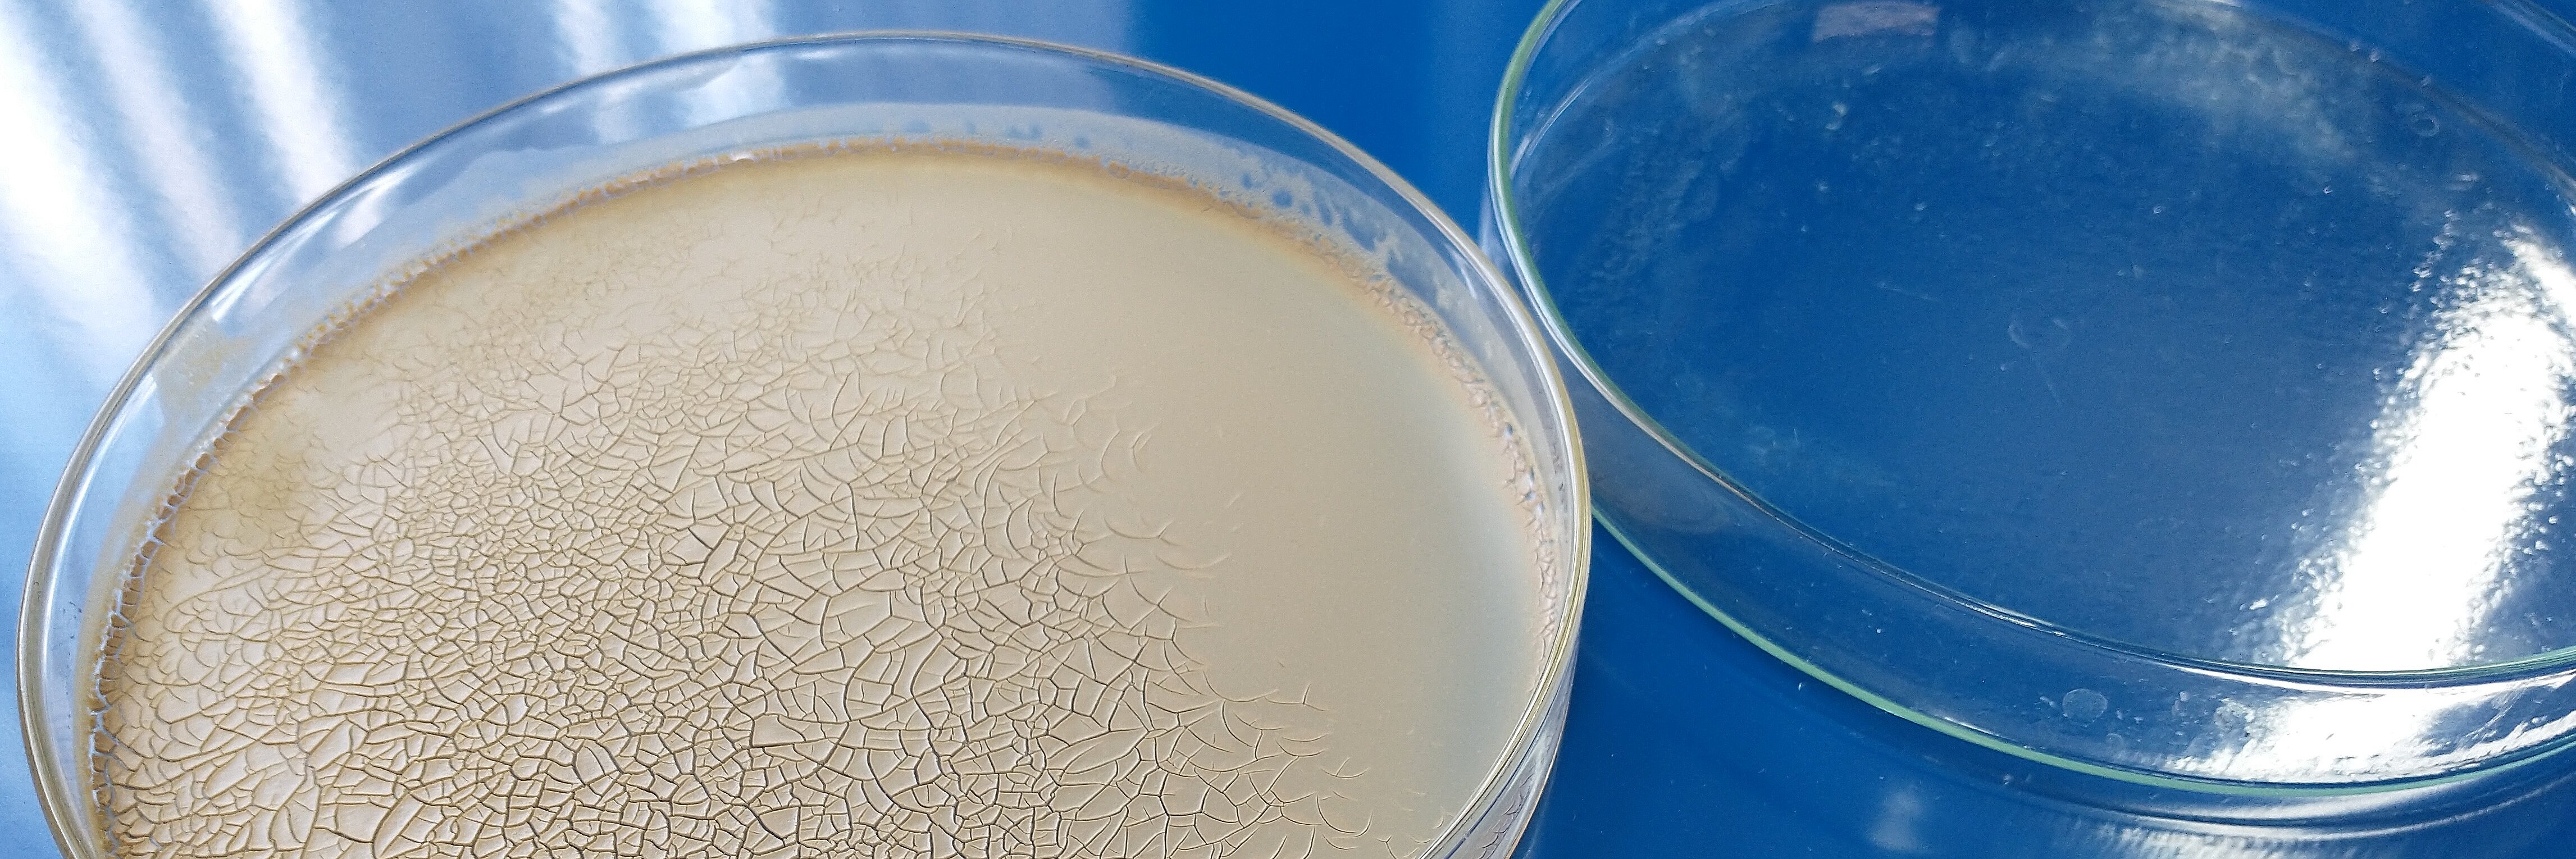

Available UV Absorbers
The available supply is characterized by the advantages and disadvantages of various organic and inorganic UV absorbers, in which no single material combines all desired properties. Organic UV absorbers do not achieve the stability of inorganic metal oxides and can be harmful to the environment as well if they enter the water column, through bathing for example. Widely available zinc oxides leave a non-transparent layer on the skin, which reduces acceptance with consumer.1 Additionally, titanium oxides are photocatalytically active and can damage other components of the formulation.2-4 There is much potential for new materials given the limitation of existing ones. In this environment our research & development team are furthering the development of UV absorbers.
Zinc oxide has unique electrical, mechanical, optical and piezoelectric properties and is mainly used as an additive in rubber and ceramic production, as a pigment or in pharmaceuticals. Due to its ability to absorb UVA and UVB radiation, it is of interest to the cosmetics industry as an active ingredient in sunscreen creams and ointments providing an alternative to the widely used titanium oxide.1-3
TiO2 absorbers are photocatalytically active, which can lead to undesirable reactions with other organic components of the formulation. Zinc oxide, on the other hand, is photocatalytically inactive, which means that the formulation remains stable over a longer period. In addition, zinc oxide absorbs radiation over the entire UV-C to UV-A range and can thus be used as a broadband filter.4
Optimization of Zinc Oxide for Increased Transparency
A disadvantage of zinc oxide is that it leaves an opaque layer on the skin in macroparticular form after drying, which reduces consumer acceptance. This visual disadvantage can be remediated by reducing the zinc oxide particle size to the nanometer range (<100 nm). Individual particles then form agglomerates, which reach the sizes established as being safe, considerably above 120nm, but with improved sun protection properties when compared to single particles above 100 nm, which is our approach for UV protection with increased transparency of the protective film (figure 1).3
IBU-tec ZnO – Production and Comparison
The search for effective, scalable and resource-conserving production methods for nanoscale zinc oxide remains ongoing. Classic methods such as sol-gel and precipitation have the disadvantage of multi-stage and therefore energy- and resource-intensive production in order to obtain a product with the required properties. They are also expensive, difficult to scale and involve the use of harmful chemicals. This helps to ensure that manufacturing comes at a high cost, which often prevents large-volume applications.
A single-stage method to produce zinc oxide nanoparticles is spray pyrolysis. A raw material solution is dispersed with a carrier gas and converted into oxide in a hot gas and calcined.5,6 A special variant of spray pyrolysis can be realized in the pulsation reactor. Here, a raw material solution is dispersed with a carrier gas and treated thermally. A pulsating hot gas stream allows a significantly more homogeneous temperature profile in comparison to the classic spray pyrolysis. The individual particles are subjected to a very homogeneous temperature treatment, which leads to a narrow distribution of the particle properties.7
Due to the simple but flexible structure of the pulsation reactor, zinc oxide nanoparticles of different shapes and sizes can be generated (Figure 2). The specific surface correlates directly with the particle size. Electron microscopy (TEM) (Figure 3) shows that the product consists of agglomerated nanoparticles with primary particle diameters between 10 and 20 nm and agglomerate diameters above 120nm.
Figure 2. Specific surfaces of nanoscale IBU-tec zinc oxides, manufactured under various process conditions in the pulsation reactor.
By conveying the obtained powders into suspensions of different solids content, the particles can be deagglomerated and products can be generated for use in transparent sun protection. Radiation is absorbed in the range of 280 – 380 nm, covering the entire spectrum for the harmful solar radiation of UV-A (315 – 380 nm) and UV-B (280 – 315 nm).
In addition, our material offers increased transparency compared to a commercially available reference material and a titanium oxide-containing formulation (Figure 4).
The advantage of the zinc oxide produced in the pulsation reactor is the relative cost-efficiency of the process, coupled with the low concentration required to achieve full UV protection. In addition, the very small average particle sizes in combination with a narrow particle size distribution lead to an exceptionally high degree of transparency in the visible light spectrum. UV protection remains in place even during processing into a suspension and the material has excellent dispersion properties in both water and organic solvents.
Sources
- Future Markets Inc. The Global Market for Zinc Oxide Nanopowders www.futuremarketsinc.com/zinc-oxide-nanoparticles/ (accessed Mar 22, 2021).
- Akira, Fujishima; Tata, N.Rao and Donald A.Tryk; “Titanium dioxide photocatalysis“; Journal of Photochemistry and Photobiology C: Photochemistry Reviews; Volume 1, Issue 1, 29 June 2000, Pages 1-21
- Roger I. Bickley, Teresita Gonzalez-Carreno, John S.Lees, Leonardo Palmisano and Richard J.D.Tilley; A structural investigation of titanium dioxide photocatalysts; Journal of Solid State Chemistry; Volume 92, Issue 1, May 1991, Pages 178-190
- Picatonotto, T.; Vione, D.; Carlotti, M. E.; Gallarate, M. Photocatalytic Activity of Inorganic Sunscreens. J. Dispers. Sci. Technol. 2001, 22 (4), 381–386. doi.org/10.1081/DIS-100106943.
- Strobel, R.; Pratsinis, S. E. Flame Aerosol Synthesis of Smart Nanostructured Materials. J. Mater. Chem. 2007, 17 (45), 4743–4756. doi.org/10.1039/b711652g.
- Pratsinis, S. E. Flame Aerosol Synthesis of Ceramic Powders. Progress in Energy and Combustion Science. Elsevier Ltd January 1, 1998, pp 197–219. doi.org/10.1016/S0360-1285(97)00028-2.
- C. Hoffmann und M. Ommer: „Reaktoren für Fluid-Feststoff-Reaktionen: Pulsationsreaktoren“, in Handbuch Chemische Reaktoren: Grundlagen und Anwendungen der Chemischen Reaktionstechnik, W. Reschetilowski, Hrsg., Berlin, Heidelberg: Springer Berlin Heidelberg, 2019, pp. 1-19. https://link.springer.com/referenceworkentry/10.1007/978-3-662-56444-8_50-1